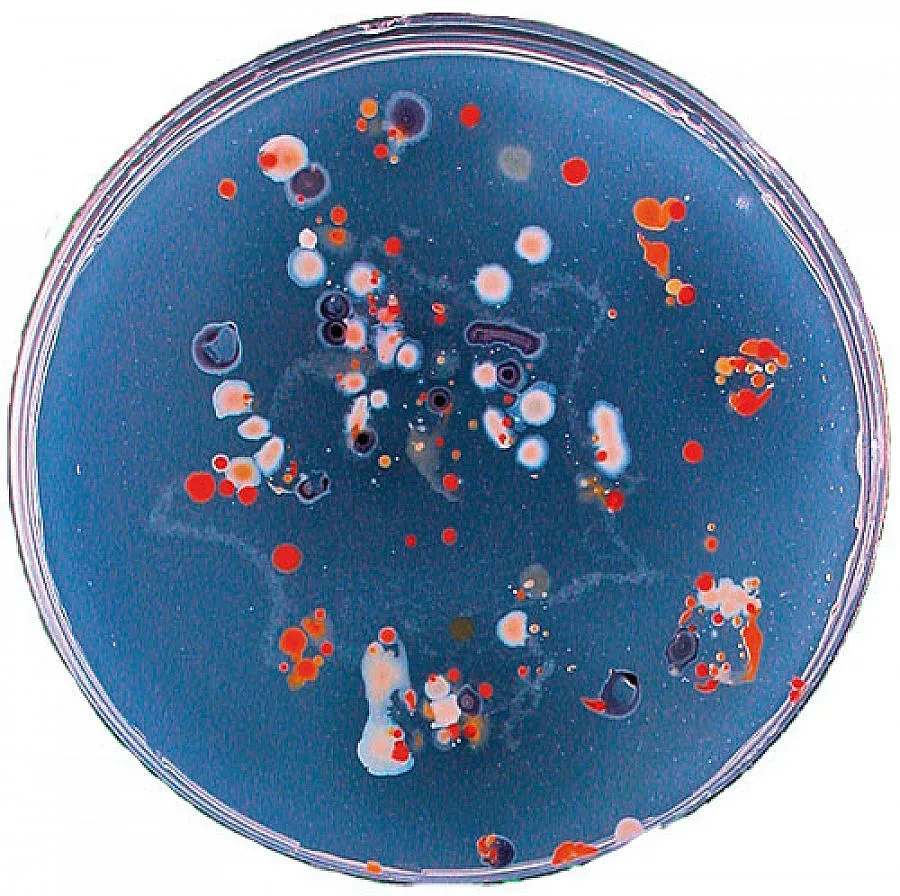
Борят инфекции с "оръжие" за 1 млн.

Пловдив.В пловдивска болница до дни ще заработи най-модерният стерилизационен блок у нас. "Оръжието" за битка с инфекциите струва 1 милион лева и се намира в МБАЛ "Пловдив", която е втората по големина лечебница под тепетата. Стерилизаторът стартира работа едновременно с 60-годишния юбилей на здравното заведение, което е едно от най-младите, но с натрупан вече сериозен опит и авторитет.
Стерилизационният блок на МБАЛ "Пловдив" е изграден със средства от Министерството на здравеопазването (МЗ), съобщи директорът на болницата д-р Аргир Аргиров. По думите му МЗ е отпуснало още 500 000 лева за отделението по анестезиология и реанимация. "Ще закупим както нови анестезиологични апарати, така и дихателни, и ехографи, и друга техника, която ще е по-надеждна както за пациентите, така и за лекарите, които работят с нея", обясни д-р Аргиров. Навръх рождения си ден болницата е ремонтирала за 200 000 лева кухненския блок, който не е обновяван в продължение на 30 г. За кухнята, която обслужва огромната 15-етажна лечебница, е купена и чисто нова техника за 70-80 хиляди лева.
Ще бъде купена и още апаратура, тъй като храненето е част от лечебно-диетичния режим на болните и е също много важно, казва болничният шеф. В тази посока предстои смяна на дограмата на цялата сграда на бул. "България". Това ще стане с пари от спечелен европроект "Козлодуй" към Министерството на икономиката, енергетиката и туризма на стойност 1,3 млн.
Пациентите ни предпочитат заради добрите ни специалисти, горд е д-р Аргиров. В бившата Окръжна болница идват хора дори от градове, в които имат университетски лечебници. Д-р Аргиров и с гордост подчертава, че нямат лекари, които напускат, за да отиват в частните клиники. Болката му обаче е, че медиците ни заминават на работа зад граница. От чужбина обаче идват и пари за заплати на млади доктори. В момента МБАЛ "Пловдив" работи по една европрограма за стажанти и има 18 места за тях. След като изтече 6-месечният срок, ще решим на кои ще предложим работа в болницата, коментира директорът. Той припомня, че в лечебницата има 23 отделения и 1 помощен сектор. МБАЛ "Пловдив" е известна с това, че приема най-тежките случаи които частните болници не се наемат да лекуват. В това е силата ни и нямаме нито един върнат пациент, казва д-р Аргиров. Признава, че за лечението на някои болни отиват по 80-100 000 лева, с което болницата влиза в преразход спрямо касата. "Колко обаче струва едни човешки живот - 50 000 лева ли", пита риторично лекарят. За юбилея на МБАЛ "Пловдив", който е на 21 ноември, той организира празнична програма. "В годините на криза гледаме да е по-стегната, но с по-малко средства пак ще постигнем същия ефект", обещава директорът. Специално за празника д-р Аргиров организира кръгла маса по проблемите на човешките ресурси. На нея ще присъстват директори на областните болници, професори, водещи специалисти в областта на медицината. Ще има и водосвет в новия параклис на МБАЛ "Пловдив". Целият персонал на здравното заведение, който е от около 800 души, ще празнува юбилея в "Новотел Пловдив".
Последвайте ни в Google News Showcase за важните новини
Вижте всички актуални новини от Standartnews.com